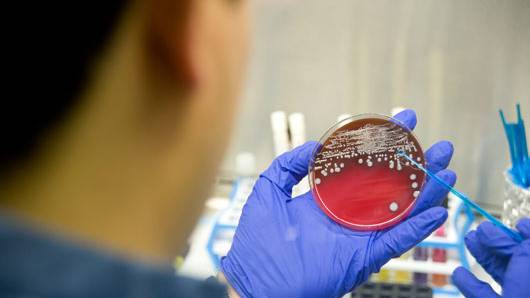
13,000 got steroid shots suspected in meningitis outbreak, number of infected at 105

13,000 got steroid shots suspected in meningitis outbreak, number of infected at 105
Source: voxxi.com

As many as 13,000 people received steroid shots suspected in a national meningitis outbreak, health officials said Monday. But it’s not clear how many are in danger.
Officials don’t how many of the shots may have been contaminated with meningitis-causing fungus. And the figure includes not only those who got them in the back for pain — who are most at risk — but also those who got the shots in other places, like knees and shoulders.
There was no breakdown on the number of back injections, said Curtis Allen, a spokesman for the Centers for Disease Control and Prevention. Those injected in joints are not believed to be at risk for meningitis, he said.
The number of people sickened in the meningitis outbreak reached 105 on Monday. Deaths rose to eight, with another fatality in Tennessee, the CDC said. Tennessee has the most cases, followed by Michigan, Virginia, Indiana, Florida, Maryland, Minnesota, North Carolina and Ohio.
Investigators suspect a steroid medication made by a specialty pharmacy may be to blame. About 17,700 single-dose vials of the steroid were sent to 23 states. Inspectors found at least one sealed vial contaminated with fungus, and tests were being done on other vials.
The first known case of the rarely seen fungal meningitis was diagnosed last month in Tennessee. The steroid maker, New England Compounding Center of Framingham, Mass., recalled the drug, and over the weekend recalled everything else it makes.
“While there is no indication at this time of any contamination in other NECC products, this recall is being taken as a precautionary measure,” the company said in a statement.
Meningitis is an inflammation of the lining of the brain and spinal cord, and a back injection would put any contaminant in more direct contact with that lining.
Symptoms on meningitis include severe headache, nausea, dizziness and fever. The CDC said many of the cases have been mild and some people had strokes. Symptoms have been appearing between one and four weeks after patients got the shots.
[...]
Read the full article at: voxxi.com